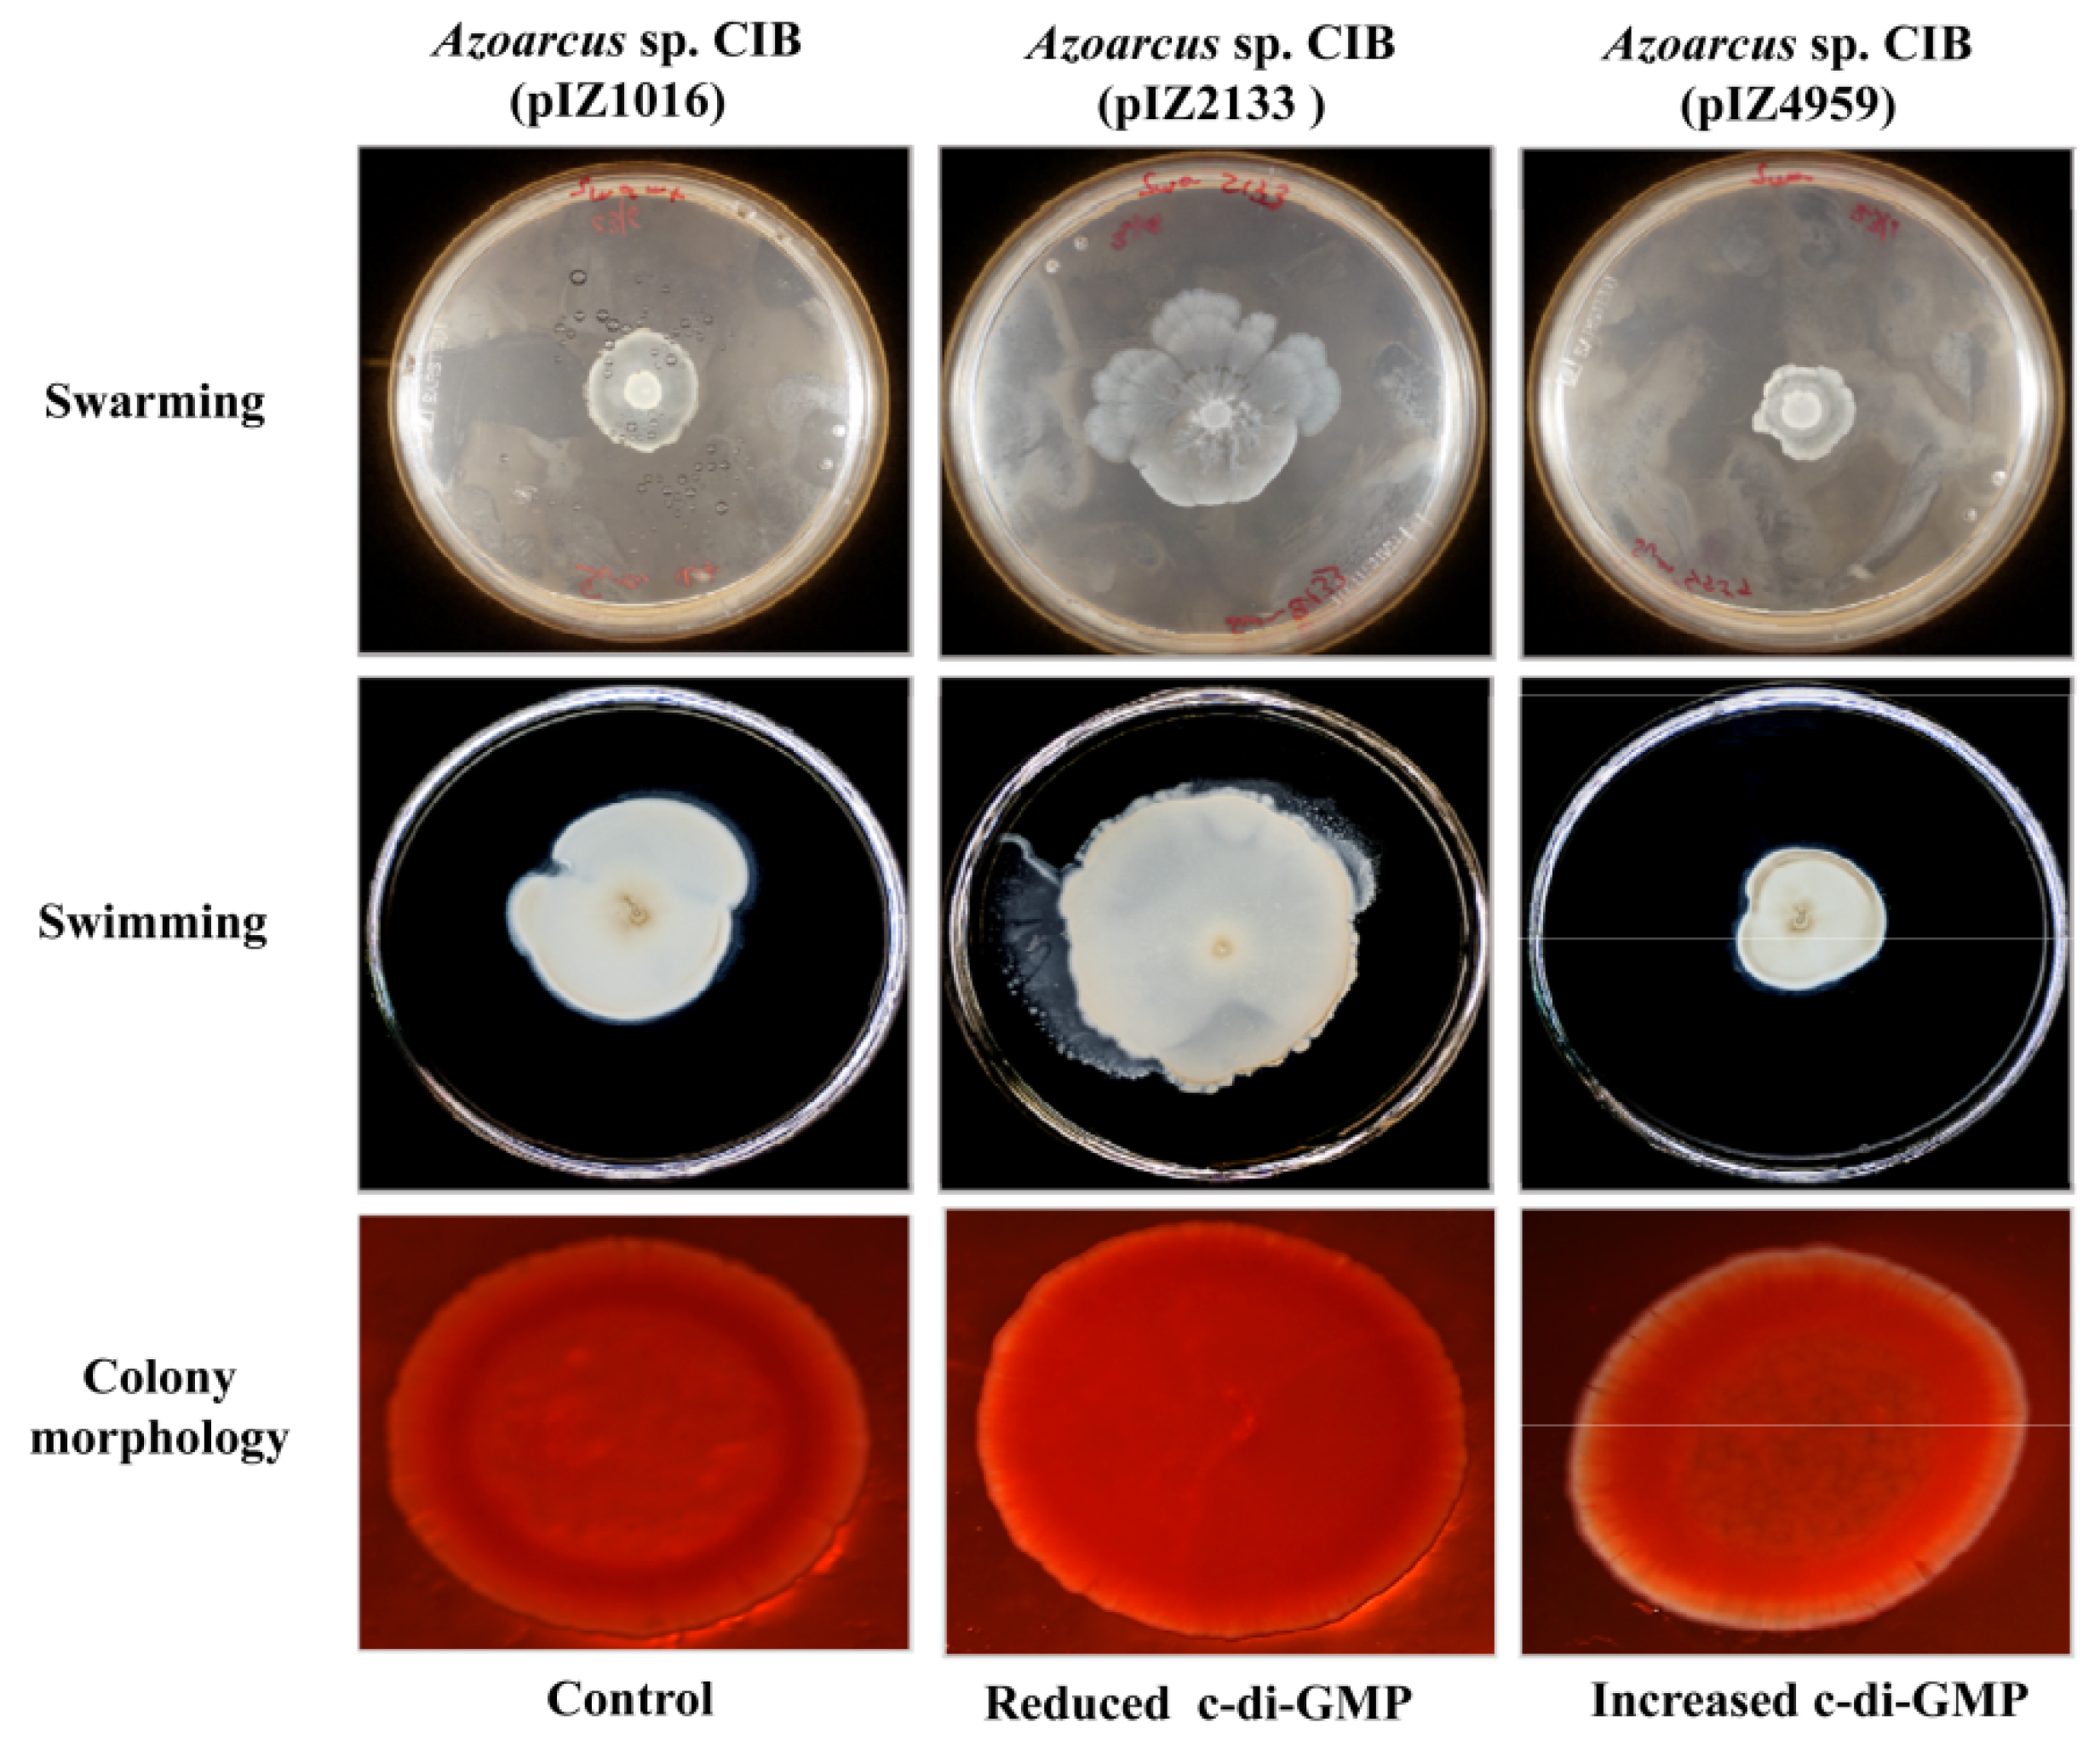
Microorganisms 09 00554 g004 Microorganisms 09 00554 g004

Motility, Adhesion and c-di-GMP Influence the Endophytic Colonization of Rice by Azoarcus sp. CIB
Abstract
1. Introduction
2. Materials and Methods
2.1. Strains, Seeds and Plasmids Used
2.2. Bacterial Growth Conditions
2.3. Molecular Biology Techniques
2.4. Construction of Azoarcus sp. CIBdpilX, Azoarcus sp. CIBdfliM and Azoarcus sp. CIBdepsF Mutant Strains
2.5. RNA Extraction and Quantitative Reverse Transcription-PCR (qRT-PCR) Experiments
2.6. Inoculation of Rice Seedlings with Bacteria
2.7. Recovery and Quantification of Endophytes
2.8. Motility Tests
2.9. Colony Morphology
2.10. Sequence Data Analyses
2.11. Statistical Analysis
3. Results and Discussion
3.1. A Functional Flagellum and Pili Type IV Are Required for Rice Colonization of Azoarcus sp. CIB
3.2. Role of the Genes Involved in Exopolysaccharide Modification in the Interaction between Azoarcus sp. CIB and Rice
3.3. c-di-GMP Levels Influence the Endophytic Lifestyle of Azoarcus sp. CIB
4. Conclusions
Supplementary Materials
Author Contributions
Funding
Institutional Review Board Statement
Informed Consent Statement
Data Availability Statement
Acknowledgments
Conflicts of Interest
References
- Bulgarelli, D.; Schlaeppi, K.; Spaepen, S.; van Themaat, E.V.L.; Schulze-Lefert, P. Structure and functions of the bacterial microbiota of plants. Annu. Rev. Plant Biol. 2013, 64, 807–838. [Google Scholar] [CrossRef]
- Reinhold-Hurek, B.; Bünger, W.; Burbano, C.S.; Sabale, M.; Hurek, T. Roots shaping their microbiome: Global hotspots for microbial activity. Annu. Rev. Phytopathol. 2015, 53, 403–424. [Google Scholar] [CrossRef] [PubMed]
- Gopal, M.; Gupta, A. Microbiome selection could spur next-generation plant breeding strategies. Front. Microbiol. 2016, 7, 1971. [Google Scholar] [CrossRef]
- Reinhold-Hurek, B.; Hurek, T. Life in the grasses: Diazotrophic endophytes. Trends Microbiol. 1998, 6, 139–144. [Google Scholar] [CrossRef]
- Rosenblueth, M.; Martínez-Romero, E. Bacterial endophytes and their interactions with hosts. Mol. Plant Microbe Interact. 2006, 19, 827–837. [Google Scholar] [CrossRef]
- Mano, H.; Morisaki, H. Endophytic bacteria in the rice plant. Microbes Environ. 2008, 23, 109–117. [Google Scholar] [CrossRef] [PubMed]
- Shidore, T.; Dinse, T.; Öhrlein, J.; Becker, A.; Reinhold-Hurek, B. Transcriptomic analysis of responses to exudates reveal genes required for rhizosphere competence of the endophyte Azoarcus sp. strain BH72. Environ. Microbiol. 2012, 14, 2775–2787. [Google Scholar] [CrossRef]
- Alquéres, S.; Meneses, C.; Rouws, L.; Rothballer, M.; Baldani, I.; Schmid, M.; Hartmann, A. The bacterial superoxide dismutase and glutathione reductase are crucial for endophytic colonization of rice roots by Gluconacetobacter diazotrophicus PAL5. Mol. Plant Microbe Interact. 2013, 26, 937–945. [Google Scholar] [CrossRef]
- Drogue, B.; Sanguin, H.; Borland, S.; Prigent-Combaret, C.; Wisniewski-Dyé, F. Genome wide profiling of Azospirillum lipoferum 4B gene expression during interaction with rice roots. FEMS Microbiol. Ecol. 2014, 87, 543–555. [Google Scholar] [CrossRef] [PubMed]
- Kaul, S.; Sharma, T.; Dhar, M.K. “Omics” tools for better understanding the plant-endophyte interactions. Front. Plant Sci. 2016, 7, 955. [Google Scholar] [CrossRef]
- Hardoim, P.R.; van Overbeek, L.S.; van Elsas, J.D. Properties of bacterial endophytes and their proposed role in plant growth. Trends Microbiol. 2008, 16, 463–471. [Google Scholar] [CrossRef]
- Hardoim, P.R.; van Overbeek, L.S.; Berg, G.; Pirttilä, A.M.; Compant, S.; Campisano, A.; Döring, M.; Sessitsch, A. The hidden world within plants: Ecological and evolutionary considerations for defining functioning of microbial endophytes. Microbiol. Mol. Biol. Rev. 2015, 79, 293–320. [Google Scholar] [CrossRef] [PubMed]
- Reinhold-Hurek, B.; Hurek, T. Living inside plants: Bacterial endophytes. Curr. Opin. Plant Biol. 2011, 14, 435–443. [Google Scholar] [CrossRef]
- Mitter, B.; Petric, A.; Shin, M.W.; Chain, P.S.G.; Hauberg-Lotte, L.; Reinhold-Hurek, B.; Nowak, J.; Sessitsch, A. Comparative genome analysis of Burkholderia phytofirmans PsJN reveals a wide spectrum of endophytic lifestyles based on interaction strategies with host plants. Front. Plant Sci. 2013, 4, 120. [Google Scholar] [CrossRef] [PubMed]
- Newman, M.A.; Sundelin, T.; Nielsen, J.T.; Erbs, G. MAMP (microbe-associated molecular pattern) triggered immunity in plants. Front. Plant Sci. 2013, 4, 139. [Google Scholar] [CrossRef] [PubMed]
- Buschart, A.; Sachs, S.; Chen, X.; Herglotz, J.; Krause, A.; Reinhold-Hurek, B. Flagella mediate endophytic competence rather than act as MAMPS in rice-Azoarcus sp. strain BH72 interactions. Mol. Plant Microbe Interact. 2012, 25, 191–199. [Google Scholar] [CrossRef] [PubMed]
- Sheibani-Tezerji, R.; Rattei, T.; Sessitsch, A.; Trognitz, F.; Mitter, B. Transcriptome profiling of the endophyte Burkholderia phytofirmans PsJN indicates sensing of the plant environment and drought stress. MBio 2015, 6, 1–11. [Google Scholar] [CrossRef] [PubMed]
- Böhm, M.; Hurek, T.; Reinhold-Hurek, B. Twitching motility is essential for endophytic rice colonization by the N2-fixing endophyte Azoarcus sp. strain BH72. Mol. Plant Microbe Interact. 2007, 20, 526–533. [Google Scholar] [CrossRef] [PubMed]
- James, E.K.; Gyaneshwar, P.; Mathan, N.; Barraquio, W.L.; Reddy, P.M.; Iannetta, P.P.M.; Olivares, F.L.; Ladha, J.K. Infection and colonization of rice seedlings by the plant growth-promoting bacterium Herbaspirillum seropedicae Z67. Mol. Plant Microbe Interact. 2002, 15, 894–906. [Google Scholar] [CrossRef]
- Danhorn, T.; Fuqua, C. Biofilm formation by plant-associated bacteria. Annu. Rev. Microbiol. 2007, 61, 401–422. [Google Scholar] [CrossRef]
- Compant, S.; Kaplan, H.; Sessitsch, A.; Nowak, J.; Ait Barka, E.; Clément, C. Endophytic colonization of Vitis vinifera L. by Burkholderia phytofirmans strain PsJN: From the rhizosphere to inflorescence tissues. FEMS Microbiol. Ecol. 2008, 63, 84–93. [Google Scholar] [CrossRef]
- Balsanelli, E.; Tuleski, T.R.; de Baura, V.A.; Yates, M.G.; Chubatsu, L.S.; de Oliveira Pedrosa, F.; de Souza, E.M.; Monteiro, R.A. Maize root lectins mediate the interaction with Herbaspirillum seropedicae via N-acetyl glucosamine residues of lipopolysaccharides. PLoS ONE 2013, 8, e77001. [Google Scholar] [CrossRef] [PubMed]
- Meneses, C.H.S.G.; Rouws, L.F.M.; Simoes-Araujo, J.L.; Vidal, M.S.; Baldani, J.I. Exopolysaccharide production is required for biofilm formation and plant colonization by the nitrogen-fixing endophyte Gluconacetobacter diazotrophicus. Mol. Plant Microbe Interact. 2011, 24, 1448–1458. [Google Scholar] [CrossRef] [PubMed]
- Schmid, J.; Sieber, V.; Rehm, B. Bacterial exopolysaccharides: Biosynthesis pathways and engineering strategies. Front. Microbiol. 2015, 6, 496. [Google Scholar] [CrossRef] [PubMed]
- Janczarek, M.; Rachwał, K.; Cieśla, J.; Ginalska, G.; Bieganowski, A. Production of exopolysaccharide by Rhizobium leguminosarum bv. trifolii and its role in bacterial attachment and surface properties. Plant Soil 2015, 388, 211–227. [Google Scholar] [CrossRef]
- Nian, H.J.; Zhang, J.; Liu, S.; Song, F.P.; Huang, D.F. Effect of bacteriaphage and exopolysaccharide on root colonization and rhizosphere competence by Pseudomonas fluorescens. Ann. Microbiol. 2010, 60, 369–372. [Google Scholar] [CrossRef]
- Römling, U.; Galperin, M.Y.; Gomelsky, M. Cyclic di-GMP: The first 25 years of a universal bacterial second messenger. Microbiol. Mol. Biol. Rev. 2013, 77, 1–52. [Google Scholar] [CrossRef]
- Jenal, U.; Reinders, A.; Lori, C. Cyclic di-GMP: Second messenger extraordinaire. Nat. Rev. Microbiol. 2017, 15, 271–284. [Google Scholar] [CrossRef]
- Hickman, J.W.; Tifrea, D.F.; Harwood, C.S. A chemosensory system that regulates biofilm formation through modulation of cyclic diguanylate levels. Proc. Natl. Acad. Sci. USA 2005, 102, 14422–14427. [Google Scholar] [CrossRef]
- Lee, V.T.; Matewish, J.M.; Kessler, J.L.; Hyodo, M.; Hayakawa, Y.; Lory, S. A cyclic-di-GMP receptor required for bacterial exopolysaccharide production. Mol. Microbiol. 2007, 65, 1474–1484. [Google Scholar] [CrossRef] [PubMed]
- Borlee, B.R.; Goldman, A.D.; Murakami, K.; Samudrala, R.; Wozniak, D.J.; Parsek, M.R. Pseudomonas aeruginosa uses a cyclic di-GMP-regulated adhesin to reinforce the biofilm extracellular matrix. Mol. Microbiol. 2010, 75, 827–842. [Google Scholar] [CrossRef] [PubMed]
- Liang, Z.X. The expanding roles of c-di-GMP in the biosynthesis of exopolysaccharides and secondary metabolites. Nat. Prod. Rep. 2015, 32, 663–683. [Google Scholar] [CrossRef] [PubMed]
- Schäper, S.; Krol, E.; Skotnicka, D.; Kaever, V.; Hilker, R.; Sǿgarrd-Andersen, L.; Becker, A. Cyclic di-GMP regulates multiple cellular functions in the symbiotic alphaproteobacterium Sinorhizobium meliloti. J. Bacteriol. 2015, 198, 521–535. [Google Scholar] [CrossRef]
- Simm, R.; Morr, M.; Kader, A.; Nimtz, M.; Römling, U. GGDEF and EAL domains inversely regulate cyclic di-GMP levels and transition from sessility to motility. Mol. Microbiol. 2004, 53, 1123–1134. [Google Scholar] [CrossRef]
- Starkey, M.; Hickman, J.H.; Ma, L.; Zhang, N.; De Long, S.; Hinz, A.; Palacios, S.; Manoil, C.; Kirisits, M.J.; Starner, T.D.; et al. Pseudomonas aeruginosa rugose small-colony variants have adaptations that likely promote persistence in the cystic fibrosis lung. J. Bacteriol. 2009, 191, 3492–3503. [Google Scholar] [CrossRef]
- Waters, C.M.; Lu, W.; Rabinowitz, J.D.; Bassler, B.L. Quorum sensing controls biofilm formation in Vibrio cholerae through modulation of cyclic di-GMP levels and repression of vpsT. J. Bacteriol. 2008, 190, 2527–2536. [Google Scholar] [CrossRef] [PubMed]
- Kazmierczak, B.I.; Lebron, M.B.; Murray, T.S. Analysis of FimX, a phosphodiesterase that governs twitching motility in Pseudomonas aeruginosa. Mol. Microbiol. 2006, 60, 1026–1043. [Google Scholar] [CrossRef]
- Wolfe, A.J.; Visick, K.L. Get the message out: Cyclic-di-GMP regulates multiple levels of flagellum-based motility. J. Bacteriol. 2008, 190, 463–475. [Google Scholar] [CrossRef]
- McCarter, L.L.; Gomelsky, M. Fifty ways to inhibit motility via cyclic di-GMP: The emerging Pseudomonas aeruginosa swarming story. J. Bacteriol. 2015, 197, 406–409. [Google Scholar] [CrossRef]
- Skotnicka, D.; Petters, T.; Heering, J.; Hoppert, M.; Kaever, V.; Sogaard-Andersen, L. c-di-GMP regulates type IV pili-dependent-motility in Myxococcus xanthus. J. Bacteriol. 2015, 198, 77–90. [Google Scholar] [CrossRef]
- Sun, Y.; Xie, Z.; Sui, F.; Liu, X.; Cheng, W. Identification of Cbp1, a c-di-GMP binding chemoreceptor in Azorhizobium caulinodans ORS571 involved in chemotaxis and nodulation of the host plant. Front. Microbiol. 2019, 10, 638. [Google Scholar] [CrossRef]
- Tischler, A.D.; Camilli, A. Cyclic diguanylate regulates Vibrio cholerae virulence gene expression. Infect. Immun. 2005, 73, 5873–5882. [Google Scholar] [CrossRef]
- Ryan, R.P. Cyclic di-GMP signalling and the regulation of bacterial virulence. Microbiology 2013, 159, 1286–1297. [Google Scholar] [CrossRef]
- Martinez-Gil, M.; Ramos, C. Role of cyclic di-GMP in the bacterial virulence and evasion of the plant immunity. Curr. Issues Mol. Biol. 2018, 25, 199–222. [Google Scholar] [CrossRef]
- Pérez-Mendoza, D.; Aragón, I.M.; Prada-Ramírez, H.A.; Romero-Jiménez, L.; Ramos, C.; Gallegos, M.T.; Sanjuán, J. Responses to elevated c-di-GMP levels in mutualistic and pathogenic plant-interacting bacteria. PLoS ONE 2014, 9, e91645. [Google Scholar] [CrossRef]
- Aragón, I.M.; Pérez-Mendoza, D.; Gallegos, M.T.; Ramos, C. The c-di-GMP phosphodiesterase BifA is involved in the virulence of bacteria from the Pseudomonas syringae complex. Mol. Plant Pathol. 2015, 16, 604–615. [Google Scholar] [CrossRef] [PubMed]
- McCarthy, Y.; Ryan, R.P.; O’Donovan, K.; He, Y.Q.; Jiang, B.L.; Feng, J.X.; Tang, J.L.; Dow, J.M. The role of PilZ domain proteins in the virulence of Xanthomonas campestris pv. campestris. Mol. Plant Pathol. 2008, 9, 819–824. [Google Scholar] [CrossRef]
- Ryan, R.P.; McCarthy, Y.; Andrade, M.; Farah, C.S.; Armitage, J.P.; Dow, J.M. Cell-cell signal-dependent dynamic interactions between HD-GYP and GGDEF domain proteins mediate virulence in Xanthomonas campestris. Proc. Natl. Acad. Sci. USA 2010, 107, 5989–5994. [Google Scholar] [CrossRef] [PubMed]
- An, S.Q.; Allan, J.H.; McCarthy, Y.; Febrer, M.; Dow, J.M.; Ryan, R.P. The PAS domain-containing histidine kinase RpfS is a second sensor for the diffusible signal factor of Xanthomonas campestris. Mol. Microbiol. 2014, 92, 586–597. [Google Scholar] [CrossRef]
- Zhang, Y.; Wei, C.; Jiang, W.; Wang, L.; Li, C.; Wang, Y.; Dow, J.M.; Sun, W. The HD-GYP domain protein RpfG of Xanthomonas oryzae pv. oryzicola regulates synthesis of extracellular polysaccharides that contribute to biofilm formation and virulence on rice. PLoS ONE 2013, 8, e59428. [Google Scholar] [CrossRef] [PubMed]
- Yang, F.; Tian, F.; Li, X.; Fan, S.; Chen, H.; Wu, M.; Yang, C.H.; He, C. The degenerate EAL-GGDEF domain protein filp functions as a cyclic di-GMP receptor and specifically interacts with the PilZ-domain protein PXO_02715 to regulate virulence in Xanthomonas oryzae pv. oryzae. Mol. Plant Microbe Interact. 2014, 27, 578–589. [Google Scholar] [CrossRef][Green Version]
- Gao, S.; Romdhane, S.B.; Beullens, S.; Kaever, V.; Lambrichts, I.; Fauvart, M.; Michiels, J. Genomic analysis of cyclic-di-GMP-related genes in rhizobial type strains and functional analysis in Rhizobium etli. Appl. Microbiol. Biotechnol. 2014, 98, 4589–4602. [Google Scholar] [CrossRef] [PubMed]
- Lim, B.; Beyhan, S.; Meir, J.; Yildiz, F.H. Cyclic-diGMP signal transduction systems in Vibrio cholerae: Modulation of rugosity and biofilm formation. Mol. Microbiol. 2006, 60, 331–348. [Google Scholar] [CrossRef]
- Ryan, R.P.; Fouhy, Y.; Lucey, J.F.; Dow, J.M. Cyclic di-GMP signaling in bacteria: Recent advances and new puzzles. J. Bacteriol. 2006, 188, 8327–8334. [Google Scholar] [CrossRef]
- Bobrov, A.G.; Kirillina, O.; Perry, R.D. The phosphodiesterase activity of the HmsP EAL domain is required for negative regulation of biofilm formation in Yersinia pestis. FEMS Microbiol. Lett. 2005, 247, 123–130. [Google Scholar] [CrossRef][Green Version]
- Fernández-Llamosas, H.; Prandoni, N.; Fernández-Pascual, M.; Fajardo, S.; Morcillo, C.; Díaz, E.; Carmona, M. Azoarcus sp. CIB, an anaerobic biodegrader of aromatic compounds shows an endophytic lifestyle. PLoS ONE 2014, 9, e110771. [Google Scholar]
- Fernández-Llamosas, H.; Ibero, J.; Thijs, S.; Imperato, V.; Vangronsveld, J.; Díaz, E.; Carmona, M. Enhancing the rice seedlings growth promotion abilities of Azoarcus sp. CIB by heterologous expression of ACC deaminase to improve performance of plants exposed to cadmium stress. Microorganisms 2020, 8, 1453. [Google Scholar] [CrossRef]
- Martín-Moldes, Z.; Zamarro, M.T.; del Cerro, C.; Valencia, A.; Gómez, M.J.; Arcas, A.; Udaondo, Z.; García, J.L.; Nogales, J.; Carmona, M.; et al. Whole-genome analysis of Azoarcus sp. strain CIB provides genetic insights to its different lifestyles and predicts novel metabolic features. Syst. Appl. Microbiol. 2015, 38, 462–471. [Google Scholar] [CrossRef]
- López-Barragán, M.J.; Carmona, M.; Zamarro, M.T.; Thiele, M.; Boll, M.; Fuchs, G.; García, J.L.; Díaz, E. The bzd gene cluster, coding for anaerobic benzoate catabolism in Azoarcus sp. CIB. J. Bacteriol. 2004, 186, 5462–5474. [Google Scholar]
- Blázquez, B.; Carmona, M.; Díaz, E. Transcriptional regulation of the peripheral pathway for the anaerobic catabolism of toluene and m-xylene in Azoarcus sp. CIB. Front. Microbiol. 2018, 9, 506. [Google Scholar] [CrossRef] [PubMed]
- Fernández-Llamosas, H.; Castro, L.; Blázquez, M.L.; Díaz, E.; Carmona, M. Biosynthesis of selenium nanoparticles by Azoarcus sp. CIB. Microb. Cell. Factories 2017, 15, 109. [Google Scholar] [CrossRef] [PubMed]
- Durante-Rodríguez, G.; Fernández-Llamosas, H.; Alonso-Fernandes, E.; Fernández-Muñiz, M.N.; Muñoz-Olivas, R.; Díaz, E.; Carmona, M. ArxA from Azoarcus sp. CIB, an anaerobic arsenite oxidase from an obligate heterotrophic and mesophilic bacterium. Front. Microbiol. 2019, 10, 1699. [Google Scholar]
- Rabus, R.; Wöhlbrand, L.; Thies, D.; Meyer, M.; Reinhold-Hurek, B.; Kämpfer, P. Aromatoleum gen. nov., a novel genus accommodating the phylogenetic lineage including Azoarcus evansii and related species, and proposal of Aromatoleum aromaticum sp. nov., Aromatoleum petrolei sp. nov., Aromatoleum bremense sp. nov., Aromatoleum toluolicum sp. nov. and Aromatoleum diolicum sp. nov. Int. J. Syst. Evol. Microbiol. 2019, 69, 982–997. [Google Scholar]
- De Lorenzo, V.; Timmis, K.N. Analysis and construction of stable phenotypes in Gram-negative bacteria with Tn5- and Tn10-derived minitransposons. Methods Enzymol. 1994, 235, 386–405. [Google Scholar] [PubMed]
- Manoil, C.; Beckwith, J. TnphoA: A transposon probe for protein export signals. Proc. Natl. Acad. Sci. USA 1985, 82, 8129–8133. [Google Scholar] [CrossRef]
- Silva-Rocha, R.; Martínez-García, E.; Calles, B.; Chavarría, M.; Arce-Rodríguez, A.; de las Heras, A.; Páez-Espino, A.D.; Durante-Rodríguez, G.; Kim, J.; Nikel, P.I.; et al. The standard european vector architecture (SEVA): A coherent platform for the analysis and development of complex prokaryotic phenotypes. Nucleic Acids Res. 2013, 41, D666–D675. [Google Scholar] [CrossRef]
- Moreno-Ruiz, E.; Hernáez, M.J.; Martínez-Pérez, O.; Santero, E. Identification and functional characterization of Sphingomonas macrogolitabida strain TFA genes involved in the first two steps of the tetralin catabolic pathway. J. Bacteriol. 2003, 185, 2026–2030. [Google Scholar] [CrossRef]
- Martín-Moldes, Z.; Blázquez, B.; Baraquet, C.; Harwood, C.S.; Zamarro, M.T.; Díaz, E. Degradation of cyclic diguanosine monophosphate by a hybrid two-component protein protects Azoarcus sp. strain CIB from toluene toxicity. Proc. Natl. Acad. Sci. USA 2016, 113, 13174–13179. [Google Scholar] [CrossRef]
- Schäfer, A.; Tauch, A.; Jäger, W.; Kalinowski, J.; Thierbach, G.; Pühler, A. Small mobilizable multi-purpose cloning vectors derived from the Escherichia coli plasmids pK18 and pK19: Selection of defined deletions in the chromosome of Corynebacterium glutamicum. Gene 1994, 145, 69–73. [Google Scholar] [CrossRef]
- Reinhold-Hurek, B.; Hurek, T.; Gillis, M.; Hoste, B.; Vancanneyt, M.; Kersters, K.; De Ley, J. Azoarcus gen. nov., nitrogen-fixing proteobacteria associated with roots of Kallar grass (Leptochloa fusca (L.) Kunth), and description of two species, Azoarcus indigens sp. nov. and Azoarcus communis sp. nov. Int. J. Syst. Bacteriol. 1993, 43, 574–584. [Google Scholar] [CrossRef]
- Miller, J.H. Experiments in Molecular Genetics; Cold Spring Harbor Laboratory Press: Cold Spring Harbor, NY, USA, 1972. [Google Scholar]
- Sambrook, J.; Rusell, D. Molecular Cloning: A Laboratory Manual; Cold Spring Harbor Laboratory Press: Cold Spring Harbor, NY, USA, 2011. [Google Scholar]
- Sanger, F.; Nicklen, S.; Coulson, A.R. DNA sequencing with chain-terminating inhibitors. Proc. Natl. Acad. Sci. USA 1977, 74, 5463–5467. [Google Scholar] [CrossRef]
- Valderrama, J.A.; Durante-Rodríguez, G.; Blázquez, B.; García, J.L.; Carmona, M.; Díaz, E. Bacterial degradation of benzoate: Cross-regulation between aerobic and anaerobic pathways. J. Biol. Chem. 2012, 287, 10494–10508. [Google Scholar] [CrossRef]
- Livak, K.J.; Schmittgen, T.D. Analysis of relative gene expression data using real-time quantitative PCR and the 2−ΔΔCT. Method. Methods 2001, 25, 402–408. [Google Scholar] [CrossRef]
- Gyaneshwar, P.; James, E.K.; Mathan, N.; Reddy, P.M.; Reinhold-Hurek, B.; Ladha, J.K. Endophytic colonization of rice by a diazotrophic strain of Serratia marcescens. J. Bacteriol. 2001, 183, 2634–2645. [Google Scholar] [CrossRef]
- Marykwas, D.L.; Berg, H.C. A mutational analysis of the interaction between FliG and FliM, two components of the flagellar motor of Escherichia coli. J. Bacteriol. 1996, 178, 1289–1294. [Google Scholar] [CrossRef][Green Version]
- Paul, K.; Nieto, V.; Carlquist, W.C.; Blair, D.F.; Harshey, R.M. The c-di-GMP binding protein YcgR controls flagellar motor direction and speed to affect chemotaxis by a “backstop brake” mechanism. Mol. Cell. 2010, 38, 128–139. [Google Scholar] [CrossRef] [PubMed]
- Morimoto, Y.; Minamino, T. Structure and function of the bi-directional bacterial flagellar motor. Biomolecules 2014, 4, 217–234. [Google Scholar] [CrossRef] [PubMed]
- Kojima, S.; Blair, D.F. The bacterial flagellar motor: Structure and function of a complex molecular machine. Int. Rev. Cytol. 2004, 233, 93–134. [Google Scholar] [PubMed]
- Anyan, M.E.; Amiri, A.; Harvey, C.W.; Tierra, G.; Morales-Soto, N.; Driscoll, C.M.; Alber, M.S.; Shrout, J.D. Type IV pili interactions promote intercellular association and moderate swarming of Pseudomonas aeruginosa. Proc. Natl. Acad. Sci. USA 2014, 111, 18013–18018. [Google Scholar] [CrossRef] [PubMed]
- Köhler, T.; Curty, L.K.; Barja, F.; van Delden, C.; Pechère, J.C. Swarming of Pseudomonas aeruginosa is dependent on cell-to-cell signaling and requires flagella and pili. J. Bacteriol. 2000, 182, 5990–5996. [Google Scholar] [CrossRef]
- Kuchma, S.L.; Griffin, E.F.; O’Toole, G.A. Minor pilins of the type IV pilus system participate in the negative regulation of swarming motility. J. Bacteriol. 2012, 194, 5388–5403. [Google Scholar] [CrossRef]
- Dörr, J.; Hurek, T.; Reinhold-Hurek, B. Type IV pili are involved in plant-microbe and fungus-microbe interactions. Mol. Microbiol. 1998, 30, 7–17. [Google Scholar] [CrossRef] [PubMed]
- Giltner, C.L.; Nguyen, Y.; Burrows, L.L. Type IV pilin proteins: Versatile molecular modules. Microbiol. Mol. Biol. Rev. 2012, 76, 740–772. [Google Scholar] [CrossRef] [PubMed]
- Chung, J.W.; Altman, E.; Beveridge, T.J.; Speert, D.P. Colonial morphology of Burkholderia cepacia complex genomovar III: Implications in exopolysaccharide production, pilus expression, and persistence in the mouse. Infect. Immun. 2003, 71, 904–909. [Google Scholar] [CrossRef] [PubMed]
- Sousa, A.M.; Machado, I.; Nicolau, A.; Pereira, M.O. Improvements on colony morphology identification towards bacterial profiling. J. Microbiol. Methods 2013, 95, 327–335. [Google Scholar] [CrossRef]
- Bordeleau, E.; Purcell, E.B.; Lafontaine, D.A.; Fortier, L.C.; Tamayo, R.; Burrus, V. Cyclic di-GMP riboswitch-regulated type IV pili contribute to aggregation of Clostridium difficile. J. Bacteriol. 2015, 197, 819–832. [Google Scholar] [CrossRef]
- Schmid, J.; Rühmann, B.; Sieber, V.; Romero-Jiménez, L.; Sanjuán, J.; Pérez-Mendoza, D. Screening of c-di-GMP-regulated exopolysaccharides in host interacting bacteria. In Methods in Molecular Biology; Medina, C., López-Baena, F., Eds.; Humana Press: New York, NY, USA, 2018; Volume 1734, pp. 263–275. [Google Scholar]
- Baker, A.E.; Webster, S.S.; Diepold, A.; Kuchma, S.L.; Bordeleau, E.; Armitage, J.P.; O’Toole, G.A. Flagellar stators stimulate c-di-GMP production by Pseudomonas aeruginosa. J. Bacteriol. 2019, 201, e00741-18. [Google Scholar] [CrossRef] [PubMed]
- Matilla, M.A.; Travieso, M.L.; Ramos, J.L.; Ramos-González, M.I. Cyclic diguanylate turnover mediated by the sole GGDEF/EAL response regulator in Pseudomonas putida: Its role in the rhizosphere and an analysis of its target processes. Environ. Microbiol. 2011, 13, 1745–1766. [Google Scholar] [CrossRef]
- Kandel, S.L.; Joubert, P.M.; Doty, S.L. Bacterial endophyte colonization and distribution within plants. Microorganisms 2017, 5, 77. [Google Scholar] [CrossRef]
- Pérez-Mendoza, D.; Sanjuán, J. Exploiting the commons: Cyclic diguanylate regulation of bacterial exopolysaccharide production. Curr. Opin. Microbiol. 2016, 30, 36–43. [Google Scholar] [CrossRef] [PubMed]
- Lin Chua, S.; Liu, Y.; Li, Y.; Jun Ting, H.; Kohli, G.S.; Cai, Z.; Suwanchaikasem, P.; Kit Go, K.K.; Pin Ng, S.; Tolker-Nielsen, T.; et al. Reduced intracellular c-di-GMP content increases expression of quorum sensing-regulated genes in Pseudomonas aeruginosa. Front. Cell Infect. Microbiol. 2017, 7, 451. [Google Scholar] [CrossRef]
- Beyhan, S.; Tischler, A.D.; Camilli, A.; Yildiz, F.H. Transcriptome and phenotypic responses of Vibrio cholerae to increased cyclic di-GMP level. J. Bacteriol. 2006, 188, 3600–3613. [Google Scholar] [CrossRef] [PubMed]
- Srivastava, D.; Harris, R.C.; Waters, C.M. Integration of cyclic di-GMP and quorum sensing in the control of vpsT and aphA in Vibrio cholerae. J. Bacteriol. 2011, 193, 6331–6341. [Google Scholar] [CrossRef] [PubMed]
- Hickman, J.W.; Harwood, C.S. Identification of FleQ from Pseudomonas aeruginosa as a c-di-GMP-responsive transcription factor. Mol. Microbiol. 2008, 69, 376–389. [Google Scholar] [CrossRef] [PubMed]
- Molina-Henares, M.A.; Ramos-González, M.I.; Daddaoua, A.; Fernández-Escamilla, A.M.; Espinosa-Urgel, M. FleQ of Pseudomonas putida KT2440 is a multimeric cyclic diguanylate binding protein that differentially regulates expression of biofilm matrix components. Res. Microbiol. 2017, 168, 36–45. [Google Scholar] [CrossRef]
- Pitzer, J.E.; Sultan, S.Z.; Hayakawa, Y.; Hobbs, G.; Miller, M.R.; Motaleb, M.A. Analysis of the Borrelia burgdorferi cyclic-di-GMP-binding protein PlzA reveals a role in motility and virulence. Infect. Immun. 2011, 79, 1815–1825. [Google Scholar] [CrossRef][Green Version]
- Russell, M.H.; Bible, A.N.; Fang, X.; Gooding, J.R.; Campagna, S.R.; Gomelsky, M.; Alexandre, G. Integration of the second messenger c-di-GMP into the chemotactic signaling pathway. MBio 2013, 4, e00001-13. [Google Scholar] [CrossRef]
- Edmunds, A.C.; Castiblanco, L.F.; Sundin, G.W.; Waters, C.M. Cyclic di-GMP modulates the disease progression of Erwinia amylovora. J. Bacteriol. 2013, 195, 2155–2165. [Google Scholar] [CrossRef]
- Pfeilmeier, S.; Saur, I.M.L.; Rathjen, J.P.; Zipfel, C.; Malone, J.G. High levels of cyclic-di-GMP in plant-associated Pseudomonas correlate with evasion of plant immunity. Mol. Plant. Pathol. 2016, 17, 521–531. [Google Scholar] [CrossRef]

| Strain or Plasmid | Relevant Genotype and Characteristic(s) | Reference or Source |
|---|---|---|
| E. coli strains | ||
| DH10B | F’, mcrA, Δ(mrr hsdRMS-mcrBC), Φ80lacZΔM15,ΔlacX74, deoR, recA1, araD139, Δ(ara-leu)7697, galU, galK, rpsL (Smr), endA1, nupG, | Life Technologies |
| S17-1λpir | Tpr Smr recA thi hsdRM+ RP4::2-Tc::Mu::Km, λpir phage lysogen | [64] |
| CC118 | Δ(ara-leu), araD, ΔlacX7, galE, galK, phoA20, rpoB, thi-1, rpsE, (Spr), (Rfr), argE, (Am), recA1 | [65] |
| Azoarcus strains | ||
| CIB | Wild type strain | [59] |
| CIBdpilX | KmR, CIB mutant by insertion in the pilX gene | This work |
| CIBdfliM | KmR, CIB mutant by insertion in the fliM gene | This work |
| CIBdepsF | KmR, CIB mutant by insertion in the epsF gene | This work |
| Plasmids | ||
| pSEVA237 | Kmr, ori pBBR1, harbors the gfp gene under the control of the PlexA promoter | [66] |
| pIZ1016 | Gmr, ori pBBR1MCS-5 derivative vector for cloning and expression harboring the Ptac promoter and the lacI gene | [67] |
| pIZ2133 | GmR, pIZ1016 derivative containing the gene PA2133 from P. aeruginosa PAO1 under the control of the Ptac promoter | [68] |
| pIZ4959 | GmR, pIZ1016 derivative containing the gene PP4959 from P. putida KT2440 under the control of the Ptac promoter | [68] |
| pK18mob | KmR, oriColE1, Mob+, lacZα, suicide vector for the construction of insertion mutants by homologous recombination | [69] |
| pK18mobpilX | KmR, pK18mob derivative that includes a 455 bp pilX HindIII/BamHI internal fragment | This work |
| pK18mobfliM | KmR, pK18mob derivative that includes a 512 bp fliM HindIII/BamHI internal fragment | This work |
| pK18mobepsF | KmR, pK18mob derivative that includes a 635 bp epsF HindIII/BamHI internal fragment | This work |
| Medium | Quantity per Litre of Distillated Water |
|---|---|
| MA (pH 7.5) | |
| KH2PO4 | 0.33 g |
| Na2HPO4 | 1.20 g |
| NH4Cl | 0.11 g |
| MgSO4 × 7H2O | 0.10 g |
| CaCl2 | 0.04 g |
| Trace elements (stock solution 100×) (pH 6.5) | |
| Nitrilotriacetic acid | 1.50 g |
| MgSO4 × 7H2O | 3.00 g |
| MnSO4 × 2H2O | 0.50 g |
| NaCl | 1.00 g |
| FeSO4 × 7H2O | 0.10 g |
| CoSO4 × 7H2O | 0.18 g |
| CaCl2 × 2H2O | 0.10 g |
| ZnSO4 × 7H2O | 0.18 g |
| CuSO4 × 5H2O | 0.01 g |
| KAl(SO4)2 × 12H2O | 0.02 g |
| H3BO3 | 0.01 g |
| Na2MoO × 2H2O | 0.01 g |
| NiCl2 × 6H2O | 0.025 g |
| Na2ScO3 × 5H2O | 0.30 mg |
| Vitamin solution (stock 1000×) | |
| Biotin | 20 mg |
| Folic acid | 20 mg |
| Pyridoxine-HCl | 10 mg |
| Thiamine-HCl × 2H2O | 50 mg |
| Riboflavin | 50 mg |
| Nicotinic acid | 50 mg |
| Calcium D-pantothenic acid | 50 mg |
| Vitamin B12 | 50 mg |
| p-aminobenzoic acid | 50 mg |
| Modified VM-ethanol rich medium (pH 6.8) | |
| KH2PO4 | 0.40 g |
| K2HPO4 | 0.60 g |
| NaCl | 1.10 g |
| NH4Cl | 0.50 g |
| MgSO4 × 7H2O | 0.20 g |
| CaCl2 | 26 mg |
| MnSO4 | 10 mg |
| Na2MoO4 | 2 mg |
| Fe(III)-EDTA | 66 mg |
| Yeast extract | 1.00 g |
| Bactopeptone | 3.00 g |
| Ethanol | 6.00 mL |
Publisher’s Note: MDPI stays neutral with regard to jurisdictional claims in published maps and institutional affiliations. |
© 2021 by the authors. Licensee MDPI, Basel, Switzerland. This article is an open access article distributed under the terms and conditions of the Creative Commons Attribution (CC BY) license (http://creativecommons.org/licenses/by/4.0/).
Share and Cite
Fernández-Llamosas, H.; Díaz, E.; Carmona, M. Motility, Adhesion and c-di-GMP Influence the Endophytic Colonization of Rice by Azoarcus sp. CIB. Microorganisms 2021, 9, 554. https://doi.org/10.3390/microorganisms9030554
Fernández-Llamosas H, Díaz E, Carmona M. Motility, Adhesion and c-di-GMP Influence the Endophytic Colonization of Rice by Azoarcus sp. CIB. Microorganisms. 2021; 9(3):554. https://doi.org/10.3390/microorganisms9030554
Chicago/Turabian StyleFernández-Llamosas, Helga, Eduardo Díaz, and Manuel Carmona. 2021. "Motility, Adhesion and c-di-GMP Influence the Endophytic Colonization of Rice by Azoarcus sp. CIB" Microorganisms 9, no. 3: 554. https://doi.org/10.3390/microorganisms9030554
APA StyleFernández-Llamosas, H., Díaz, E., & Carmona, M. (2021). Motility, Adhesion and c-di-GMP Influence the Endophytic Colonization of Rice by Azoarcus sp. CIB. Microorganisms, 9(3), 554. https://doi.org/10.3390/microorganisms9030554







